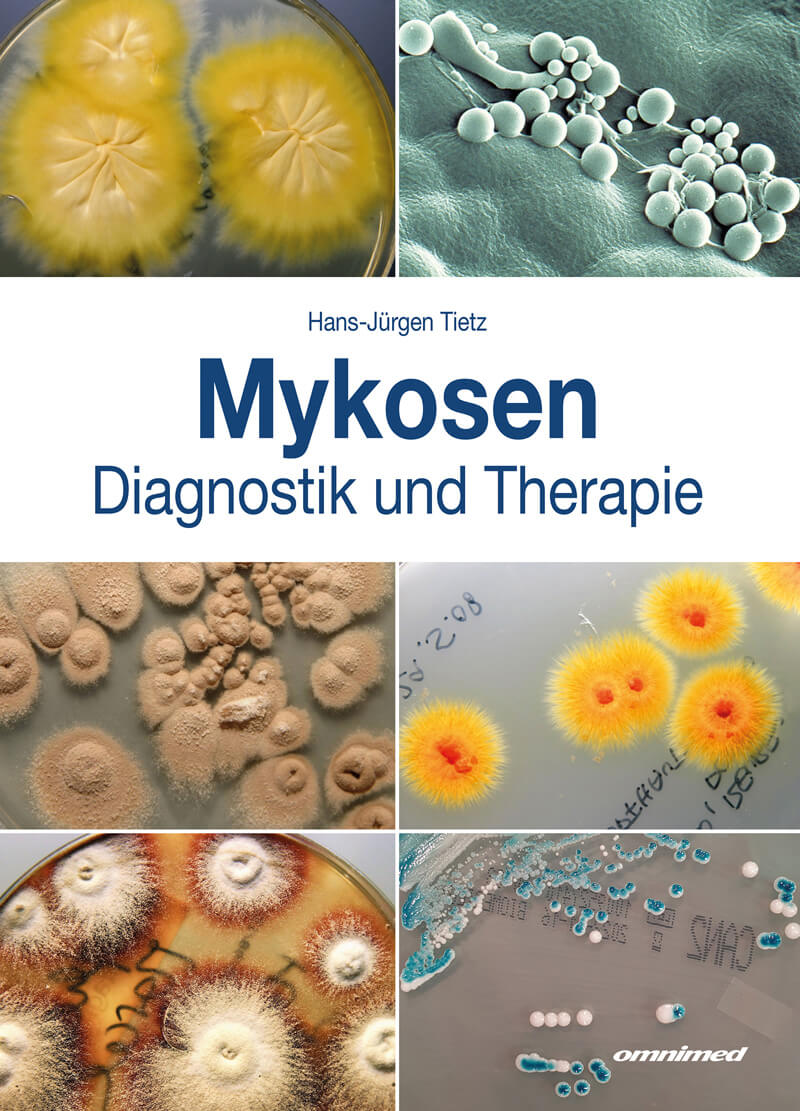

Die Mykologie ist ein liebenswertes und von Erfolgen gekröntes Fachgebiet. Ihre Erreger sind in vielen medizinischen Disziplinen, ebenso in podologischen Praxen und Apotheken zu Hause.
Dank moderner diagnostischer Methoden und therapeutischer Konzepte sind die Möglichkeiten, Mykosen sicher zu erkennen und erfolgreich zu behandeln, besser denn je.
Das Fundament der Diagnostik ist die PCR, das Herzstück der Therapie das Zusammenspiel von inneren und äußeren Behandlungen. Jede Mykose kann auf dieser Grundlage geheilt werden. Mit dieser Gewissheit, liebe Leser, freuen Sie sich auf jeden Mykose-Patienten, der Ihre Hilfe sucht.
Hardcover, 104 Seiten,
278 farbige Abbildungen
ISBN-13: 978-3-931766-49-8
Preis: 119 €
inkl. 7 % MwSt. zzgl. Porto